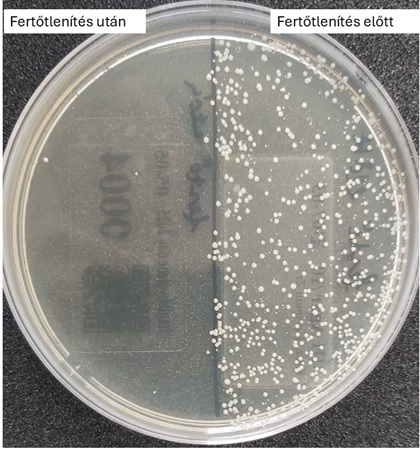

A Debreceni Egyetem Egészségtudományi Kar Egy Egészség Intézetének szervezésében, a Klinikai Központ Kórházhigiénés Osztályának és a Hand in Scan támogatásával és együttműködésével valósult meg a WHO Kézhigiénés Világnapja alkalmából tartott figyelemfelkeltő esemény, amely játékos, mégis edukatív módon hívta fel a figyelmet a kézhigiéné fontosságára.
Balról: Nagy Vivien, Buzgó Lilla, Középen: Bőkényné Tóth Renáta, Jobbról: Kádár-Szeőcs Dóra, Nagy Dezső (Hand in Scan)
A programon az érdeklődők számos interaktív programon keresztül mélyíthették el tudásukat:
- Varázspor – Tedd láthatóvá a láthatatlant!
Egy speciális UV-por segítségével a látogatók vizuálisan is érzékelhették, milyen könnyen terjednek a kórokozók hétköznapi tárgyakon keresztül.
- Tenyerünk titkos élete
Mikrobiológiai tenyésztéssel szemléltettük, mennyire hatékony a kézmosás és fertőtlenítés – a résztvevők kézzelfogható bizonyítékot kaptak a higiénés gyakorlatuk eredményességéről.
Egy látogató kezéről vett mintából kitenyésztett mikroorganizmusok
- Kézhigiénés Kvízjáték
A résztvevők tudásukat tesztelhették egy szórakoztató kvízben.
- Kis kezek, nagy üzenetek
A gyermeki kreativitás került fókuszba a kézhigiénés rajzverseny legjobb alkotásain keresztül, melyek látványos formában hívták fel a figyelmet a kézmosás fontosságára.
- Semmelweis Scanner™ – A kézhigiénés tudatosság új dimenziója
A rendezvény kiemelt szakmai attrakciója a Hand in Scan által biztosított Semmelweis Scanner™ volt, amely valós idejű, objektív visszajelzést adott a kézfertőtlenítés hatékonyságáról. Az eszköz nemcsak oktatási célokat szolgál, hanem a minőségbiztosítás eszközeként is hozzájárul a higiénés kultúra fejlesztéséhez.
A Semmelweis Scanner™ által rögzített kézhigiénés ellenőrzés eredménye
Továbbá szeretnénk köszönetünket kifejezni mindazoknak, akik a háttérben támogatták a rendezvény megvalósulását: Tóth Andreának (Kórházhigiénés Osztály), Cserés-Varga Kincsőnek (Kórházhigiénés Osztály), dr. Gömöri Gabriellának (Kórházhigiénés Osztály) és Freytag Csongornak (Egy Egészség Intézet).
A szervezők bíznak abban, hogy az esemény hozzájárult a kézhigiénia iránti tudatosság növeléséhez a jövő szakembereinek körében.
Ne feledjük a jelszót: Moss kezet! Ments életet!